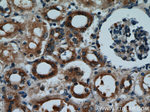
SH3D19 Antibody in Immunohistochemistry (Paraffin) (IHC (P))

Search
Proteintech
SH3D19 Polyclonal Antibody
{{$productOrderCtrl.translations['antibody.pdp.commerceCard.promotion.promotions']}}
{{$productOrderCtrl.translations['antibody.pdp.commerceCard.promotion.viewpromo']}}
{{$productOrderCtrl.translations['antibody.pdp.commerceCard.promotion.promocode']}}: {{promo.promoCode}} {{promo.promoTitle}} {{promo.promoDescription}}. {{$productOrderCtrl.translations['antibody.pdp.commerceCard.promotion.learnmore']}}
产品信息
21499-1-AP
种属反应
宿主/亚型
分类
类型
抗原
偶联物
形式
浓度
规格
纯化类型
保存液
内含物
保存条件
运输条件
产品详细信息
Immunogen sequence: VLVMLKQTE NNYLECQKGE DTGRVHLSQM KIITPLDEHL RSRPNDPSHA QKPVDSGAPH AVVLHDFPAE QVDDLNLTSG EIVYLLEKID TDWYRGNCRN QIGIFPANYV KVIIDIPEGG NGKRECVSSH CVKGSRCVAR FEYIGEQKDE LSFSEGEIII LKEYVNEEWA RGEVRGRTGI FPLNFVEPVE DYPTSGANVL STKVPLKTKK EDSGSNSQVN SLPAEWCEAL HSFTAETSDD LSFKRGDRIQ ILERLDSDWC RGRLQDREGI FPAVFVRPCP AEAKSMLAIV PKGRKAKALY DFRGENEDEL SFKAGDIITE LESVDDDWMS GELMGKSGIF PKNYIQFLQI S (411-790 aa encoded by BC108890)
靶标信息
May play a role in regulating A disintegrin and metalloproteases (ADAMs) in the signaling of EGFR-ligand shedding. May be involved in suppression of Ras-induced cellular transformation and Ras-mediated activation of ELK1. Plays a role in the regulation of cell morphology and cytoskeletal organization.
仅用于科研。不用于诊断过程。未经明确授权不得转售。
篇参考文献 (0)
生物信息学
蛋白别名: ADAM-binding protein Eve-1; EBP; EEN-binding protein; Kryn; SH3 domain containing 19; SH3 domain containing protein D 19; SH3 domain protein D19; SH3 domain-containing protein 19; unnamed protein product
基因别名: AW011754; EBP; Eve-1; EVE1; Kryn; RGD1304885; SH3D19; SH3P19
UniProt ID: (Human) Q5HYK7, (Mouse) Q91X43
Entrez Gene ID: (Human) 152503, (Mouse) 27059, (Rat) 295171